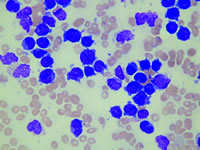
����������ϸ����Ѫ�����ߴ��ڳ�Ѫ��Ѫ˨�γ�˫��Σ������Ӱ��������Ŀǰ������Ч��Ԥ��ʩ

急性早幼粒细胞白血病患者存在出血和血栓形成双重危险严重影响治疗且目前尚无有效干预措施
|
美国西北大学Feinberg医学院Tallman 等进行的研究表明,急性早幼粒细胞白血病(APL)有出血和血栓形成的双重危险,这也是影响患者治疗的主要因素。[Semin Thromb Hemost 2007,33(4)∶330]
APL是目前成人急性髓性白血病中最有可能治愈的一种亚型。经过全反式维A酸(ATRA) 联合蒽环类抗生素为基础的化疗后,患者治愈率有望达到近70%~90%。患者早期的死亡多数是由脑内严重、频繁的出血引起,这也是治疗失败的主要原因。目前,我们对诊断或治疗过程中血栓形成的认识仍不完全,也反映了凝血障碍的复杂性。
有研究结果显示,出血和血栓形成的双重危险至少是以下三个因素造成的,即弥散性血管内凝血(DIC),纤维蛋白溶解(部分是由于APL细胞膜表面膜连蛋白-Ⅱ的表达形成)及纤维蛋白素原和血管假性血友病因子等蛋白的直接水解。
还有研究提示,最重要的治疗策略是在诊断中开始怀疑时就尽早使用ATRA(不必等到遗传方面的证实),并在诱导期间使用血液制品,因为ATRA和三氧化二砷均可使凝血障碍迅速解除。初步研究表明抗纤溶药物的常规使用并不能发挥作用。肝素曾是APL患者的主要治疗手段,但现在几乎摒弃不用。, http://www.100md.com